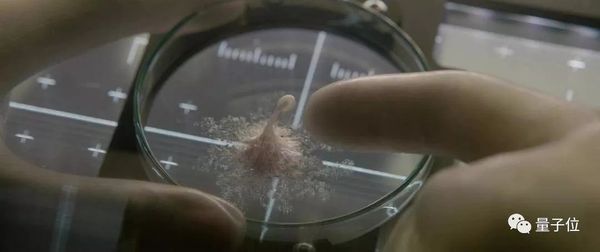

首个活体机器人诞生,外媒:毛骨悚然
凤凰网
以下文章来源于量子位 ,作者关注前沿科技
鱼羊 十三 发自 凹非寺
量子位 报道 | 公众号 QbitAI
本文经AI新媒体量子位(公众号 ID: QbitAI)授权转载,转载请联系出处。
全球首个用细胞做成的活体机器人,已经诞生了。
不是设想,不是科幻,是实实在在登上顶级期刊的科学研究。

而且不用金属、塑料打造,采用青蛙表皮细胞和心脏细胞重组。
这就是顶级期刊《美国科学院院报》(PNAS)最新发表的惊人研究,来自美国佛蒙特大学和塔弗茨大学团队。
论文通讯作者约书亚·邦加(Joshua Bongard)说:
它们既不是传统的机器人,也不是已知的动物物种。这是一种活的、可编程的有机体。
合著者迈克尔·莱文(Michael Levin)也表示:
这是全新的生命形式。它们从未在地球上出现过。
这些机器人,被命名为Xenobots。
研究者认为,其在水性介质中行动的特性,展示了未来无限的可能性:清理海洋中的微塑料污染,作为可生物降解的药物输送机器人等等。
但当它被展示在大众面前时,立即引起了许多人的恐慌。
是的,有科幻电影《异形》、《异星觉醒》内味了。网友纷纷表示:吓死我了。

外媒《连线》则用四个字来形容:毛骨悚然。
活体机器人,到底是怎么一回事?
Xenobots:首个活体机器人
这个名叫Xenobot的“异形机器人”,长度不到1毫米,是非洲爪蛙心脏细胞(收缩细胞)和表皮细胞(被动细胞)的结合。
结合的依据,是佛蒙特大学的超级计算机集群Deep Green设计出来的模型。
研究人员在这个具有20000台笔记本电脑计算能力的集群上演算了一种进化算法。
在反复试验当中,用类似自然选择的方式,将性能较差的模型设计剔除。
代码已开源,地址见文末

这两种细胞都是研究人员从爪蛙胚胎干细胞中分化得到的。

研究人员先将胚胎细胞切开。

细胞被切开的两个部分,单独进行培养。

而后将二者慢慢进行重建。

最后,按照超级计算机模拟出来的设计,用镊子和电极对这个重塑的细胞进行“雕琢”。

所重塑的细胞形状各异,有的是楔形,有的是拱形。
在下图中,顶部的绿色部分是被动细胞,而底部红、绿交替的部分便是主动细胞。

▎绿色为表皮细胞,红色为心脏细胞
通过心脏细胞产生的收缩,Xenobot能在水性介质中移动。

▎已调整为8倍速
不单单能直线行进,也能转圈圈。

不同于金属、塑料打造的机器人,Xenobot是完全可生物降解的。
并且,它还具有自我修复能力。

论文通讯作者Joshua Bongard介绍:
我们把机器人切成了两半,结果它不仅能把自己缝合起来,其后还能继续活动。
有趣的是,如果你将这个机器人翻转过来,它就像乌龟翻了个个儿背朝下,会失去移动能力。
计算机+生物,跨界合作
这项研究由佛蒙特大学计算机科学系教授约书亚·邦加的团队主导。
论文一作是山姆·克里格曼。佛蒙特大学博士研究生,致力于进化机器人的研究。

▎山姆·克里格曼(Sam Kriegman)
通讯作者约书亚·邦加教授博士毕业于苏黎世大学,现在是佛蒙特大学计算机科学系教授,形态演化与认知实验室负责人,研究重点是进化机器人技术,进化计算和物理模拟。

▎约书亚·邦加(Josh Bongard)
而组装机器人的工作,主要由塔夫茨大学生物系教授迈克尔·莱文团队完成。

▎迈克尔·莱文(Michael Levin)
异星觉醒?
研究者们认为,Xenobot的特性展示了其未来无限的可能性。它们可以被用来清理海洋中的微塑料污染,定位和消化有毒物质,或者进入人体血管,精准输送药物、清除动脉壁上的斑块等等。
但或许,这样的一个“异形”机器人,会让你想起科幻电影《异星觉醒》:一个单细胞就能毁天灭地。
已经有网友表示受到了惊吓:

论文一作山姆·克里格曼(Sam Kriegman)坦承,这项研究带来了新的道德问题:这类机器人的未来变体可能具有神经系统和认知能力。
我认为重要的是,这项研究是公开的,社会可以对其进行讨论,政策制定者也能有针对性地制定最佳行动方案。
论文的另一位作者,塔夫茨大学教授迈克尔·莱文(Michael Levin)也指出,这种恐惧并非不合理。但他认为,他们的工作是在帮助人们更好地理解这类系统。
这项研究正是对人们所担忧的事情的直接贡献。
你怎么看呢?
传送门
论文地址:
https://www.pnas.org/content/early/2020/01/07/1910837117
Github项目:
https://github.com/skriegman/reconfigurable_organisms
参考链接:
https://www.wired.com/story/xenobot/
https://www.inverse.com/article/62220-scientists-create-living-machine
https://www.cnet.com/news/tiny-living-robots-made-from-frog-cells-could-soon-swim-inside-your-body/#ftag=CADf328eec
https://www.theguardian.com/science/2020/jan/13/scientists-use-stem-cells-from-frogs-to-build-first-living-robots?utm_term=Autofeed&CMP=twt_gu&utm_medium=&utm_source=Twitter#Echobox=1578950205
— 完 —
评论列表 共有 0 条评论
最新导读

热门文章
















发表评论 取消回复